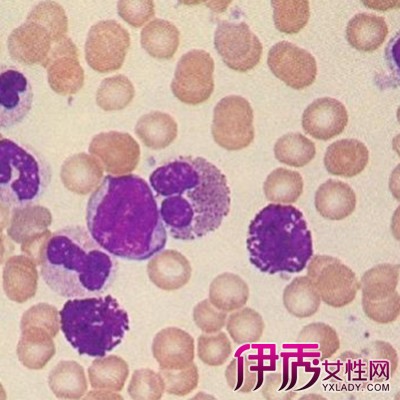

2.化疗
化疗是治疗急性白血病的主要手段。化疗可分为诱导缓解治疗和缓解后治疗两个阶段,其间可增加强化治疗、巩固治疗和中枢神经预防治疗等。
缓解诱导是大剂量多种药物联用的强烈化疗,以求迅速大量杀伤白血病细胞,控制病情,达到完全缓解,为以后的治疗打好基础。所谓完全缓解,是指白血病的症状,体征完全消失,血象和骨髓象基本上恢复正常。缓解后治疗目的在于巩固治疗和维持强化治疗,最后达到疾病的治愈。巩固治疗是在诱导缓解治疗患者获得缓解以后进行,原则上选用原诱导化疗方案继续进行1~2个疗程。维持巩固治疗是在诱导缓解治疗使患者获得完全缓解并经巩固治疗后进行,以期继续最大量地杀灭残留体内的白血病细胞。中枢神经预防性治疗宜在诱导治疗出现缓解后立即进行,以避免和减少中枢神经系统白血病发生,一个完整的治疗方案应遵循上述原则进行。
3.骨髓移植
(1)同基因骨髓移植 供者为同卵孪生子。
(2)同种异基因骨髓移植 供者为患者的兄弟姐妹或无关供者。
(3)自体骨髓移植 不需选择供者,易推广。
(4)外周血造血干细胞和脐血移植 可有自体和异基因两种供者来源。